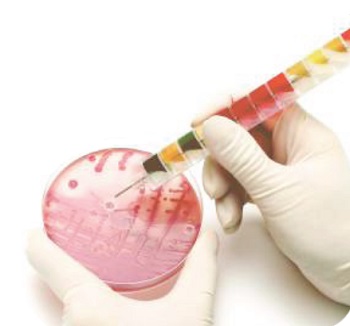

Cargando, por favor espere ...

Material para ensayos y análisis microbiológicos
| Código | Descripción | Disponibilidad | Precio 1x (€) |
Cantidad | Añadir | Precio 1x caja (€) |
Cantidad caja |
Añadir |
|---|---|---|---|---|---|---|---|---|
| 2135100044 | EnteroPluri-Test, 10 tests, Sistema con 12 medios de Agar por inoculaciˇn simultßnea para identificaciˇn de Enterobacteriaceae / Enterobacterias, LIOFILCHEM® | 5/12 días | 134,55 | 1 | 72,24 | 5 | ||
| 2135100045 | EnteroPluri-Test, 25 tests, Sistema con 12 medios de Agar por inoculaciˇn simultßnea para identificaciˇn de Enterobacteriaceae / Enterobacterias, LIOFILCHEM® | 5/12 días | 212,52 | 1 | 138,67 | 5 | ||
| 2135100046 | Voges Proskauer (V.P.) TEST EP, 100/200 tests, LIOFILCHEM® | 5/12 días | 98,67 | 1 | 36,36 | 5 | ||
| 2135100047 | KOH y alfa-naftol para ensayo de Voges Proskauer, 2 x 10 x cuentagotas 2 mL, LIOFILCHEM® | 5/12 días | 143,18 | 1 | 80,87 | 5 | ||
| 2135100048 | KOVAC?S - Reactivo, 800/1000 test, LIOFILCHEM® | 5/12 días | 96,78 | 1 | 34,48 | 5 | ||
| 2135100049 | Soluciˇn de reactivo para tests indol, 20 x cuentagotas 2.5 mL, LIOFILCHEM® | 5/12 días | 143,18 | 1 | 80,87 | 5 | ||
| 2135100050 | EnteroPluri-Test, libro de cˇdigos, LIOFILCHEM® | 5/12 días | 91,43 | 1 | 29,12 | 5 | ||
| 2135100051 | Oxi / Ferm Pluri Test, 10 tests, Sistema para identificaciˇn de bacterias Gram negativas y positivas a la oxidasa, LIOFILCHEM® | 5/12 días | 140,42 | 1 | 78,11 | 5 | ||
| 2135100052 | Oxi / Ferm Pluri Test, 25 tests, Sistema para identificaciˇn de bacterias Gram negativas y positivas a la oxidasa, LIOFILCHEM® | 5/12 días | 200,97 | 1 | 138,67 | 5 | ||
| 2135100053 | Oxi / Ferm Pluri Test, libro de cˇdigos, LIOFILCHEM® | 5/12 días | 91,43 | 1 | 29,12 | 5 | ||
| 2135100054 | Anaerobe System, 20 tests, sistema de 24 pocillos para identificaciˇn bioquÝmica de microorganismos anaerobios, LIOFILCHEM® | 5/12 días | 222,53 | 1 | 160,22 | 5 | ||
| 2135100055 | Nitrate Test, test de nitratos, LIOFILCHEM® | 5/12 días | 93,15 | 1 | 30,84 | 5 | ||
| 2135100056 | Reactivo de KOVAC'S, 800/1000 tests, LIOFILCHEM® | 5/12 días | 96,78 | 1 | 34,48 | 5 | ||
| 2135100057 | Reactivo perˇxido de hidrˇgeno H2O2, LIOFILCHEM® | 5/12 días | 85,05 | 1 | 22,75 | 5 | ||
| 2135100058 | Entero System 18 R, 20 tests, Sistema con 18 tests bioquÝmicos desecados en pocillos para identificaciˇn de Enterobacteriaceae / Enterobacterias, LIOFILCHEM® | 5/12 días | 139,73 | 1 | 77,42 | 5 | ||
| 2135100059 | Entero System 18 R, 4 tests, Sistema con 18 tests bioquÝmicos desecados en pocillos para identificaciˇn de Enterobacteriaceae / Enterobacterias, LIOFILCHEM® | 5/12 días | 89,70 | 1 | 27,39 | 5 | ||
| 2135100060 | Consultar | Consultar | --- | |||||
| 2135100061 | Entero System 18 R, libro de cˇdigos, LIOFILCHEM® | 5/12 días | 93,15 | 1 | 30,84 | 5 | ||
| 2135100062 | Entero System 24R, 20 tests, Sistema con 24 tests bioquÝmicos desecados en pocillos para identificaciˇn de Enterobacteriaceae / Enterobacterias, LIOFILCHEM® | 5/12 días | 160,43 | 1 | 98,12 | 5 | ||
| 2135100063 | Listeria System 18 R, 20 tests, Sistema con 18 ensayos bioquÝmicos desecados en pocillos para identifiaciˇn de Listeria spp., LIOFILCHEM® | 5/12 días | 139,73 | 1 | 77,42 | 5 | ||
| 2135100064 | Listeria System 18 R, 4 tests, Sistema con 18 ensayos bioquÝmicos desecados en pocillos para identifiaciˇn de Listeria spp., LIOFILCHEM® | 5/12 días | 89,70 | 1 | 27,39 | 5 | ||
| 2135100065 | Listeria System 18 R - REAGENT, 100/200, Reactivos bioquÝmicos adicionales para sistemas Listeria System 18 R, LIOFILCHEM® | 5/12 días | 125,93 | 1 | 63,62 | 5 | ||
| 2135100066 | Staf System 18 R, 20 tests, Sistema con 18 ensayos bioquÝmicos desecados en pocillos para identificaciˇn de estafilococos, LIOFILCHEM® | 5/12 días | 139,73 | 1 | 77,42 | 5 | ||
| 2135100067 | Staf System 18 R, 4 tests, Sistema con 18 ensayos bioquÝmicos desecados en pocillos para identificaciˇn de estafilococos, LIOFILCHEM® | 5/12 días | 89,70 | 1 | 27,39 | 5 | ||
| 2135100068 | IDENTIFICATION System - REAGENT, 100/200, Reactivos bioquÝmicos adicionales para sistemas de identificaciˇn, LIOFILCHEM® | 5/12 días | 143,18 | 1 | 80,87 | 5 | ||
| 2135100069 | Strepto System 12R, 40 tests, Sistema con 12 pruebas bioquÝmicas desecadas en pocillos para identificaciˇn de estreptococos, LIOFILCHEM® | 5/12 días | 147,50 | 1 | 85,19 | 5 | ||
| 2135100070 | Strepto System 12R, 8 tests, Sistema con 12 pruebas bioquÝmicas desecadas en pocillos para identificaciˇn de estreptococos, LIOFILCHEM® | 5/12 días | 91,43 | 1 | 29,12 | 5 |